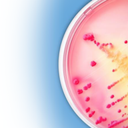
SYNLOGIC, INC.

Synlogic, Inc.
Synlogic, Inc., a biopharmaceutical company, engages in the discovery and development of synthetic biotics to treat metabolic diseases in the United States. Its pipeline include SYNB1618 for the treatment of phenylketonuria; SYNB1353, an orally administered, non-systemically absorbed drug candidate, which is in Phase I clinical to treat homocystinuria; SYNB8802, an orally administered, non-systemically absorbed drug candidate for the treatment of enteric hyperoxaluria; and SYNB2081 to lower uric acid for the potential treatment of gout. The company has a collaboration agreement with F. Hoffmann-La Roche Ltd and Hoffmann-La Roche Inc.; and Ginkgo Bioworks, Inc. Synlogic, Inc. is based in Winchester, Massachusetts.
Stock Performance (90 Days)
Layoff History
Recent News
Other Biotechnology Companies
View All →Frequently Asked Questions
Has SYNLOGIC, INC. had layoffs?
How many employees does SYNLOGIC, INC. have?
What industry is SYNLOGIC, INC. in?
Is SYNLOGIC, INC. a publicly traded company?
Where is SYNLOGIC, INC. headquartered?
Disclaimer
Data aggregated from public sources including WARN notices, SEC filings, press releases, and market data. While we strive for accuracy, information is provided "as-is" for informational purposes only. Always verify critical information with official company sources.
This information does not constitute investment, financial, legal, or career advice. See our Terms of Service, Privacy Policy, and About page for more information.
Found an error? Report it here.